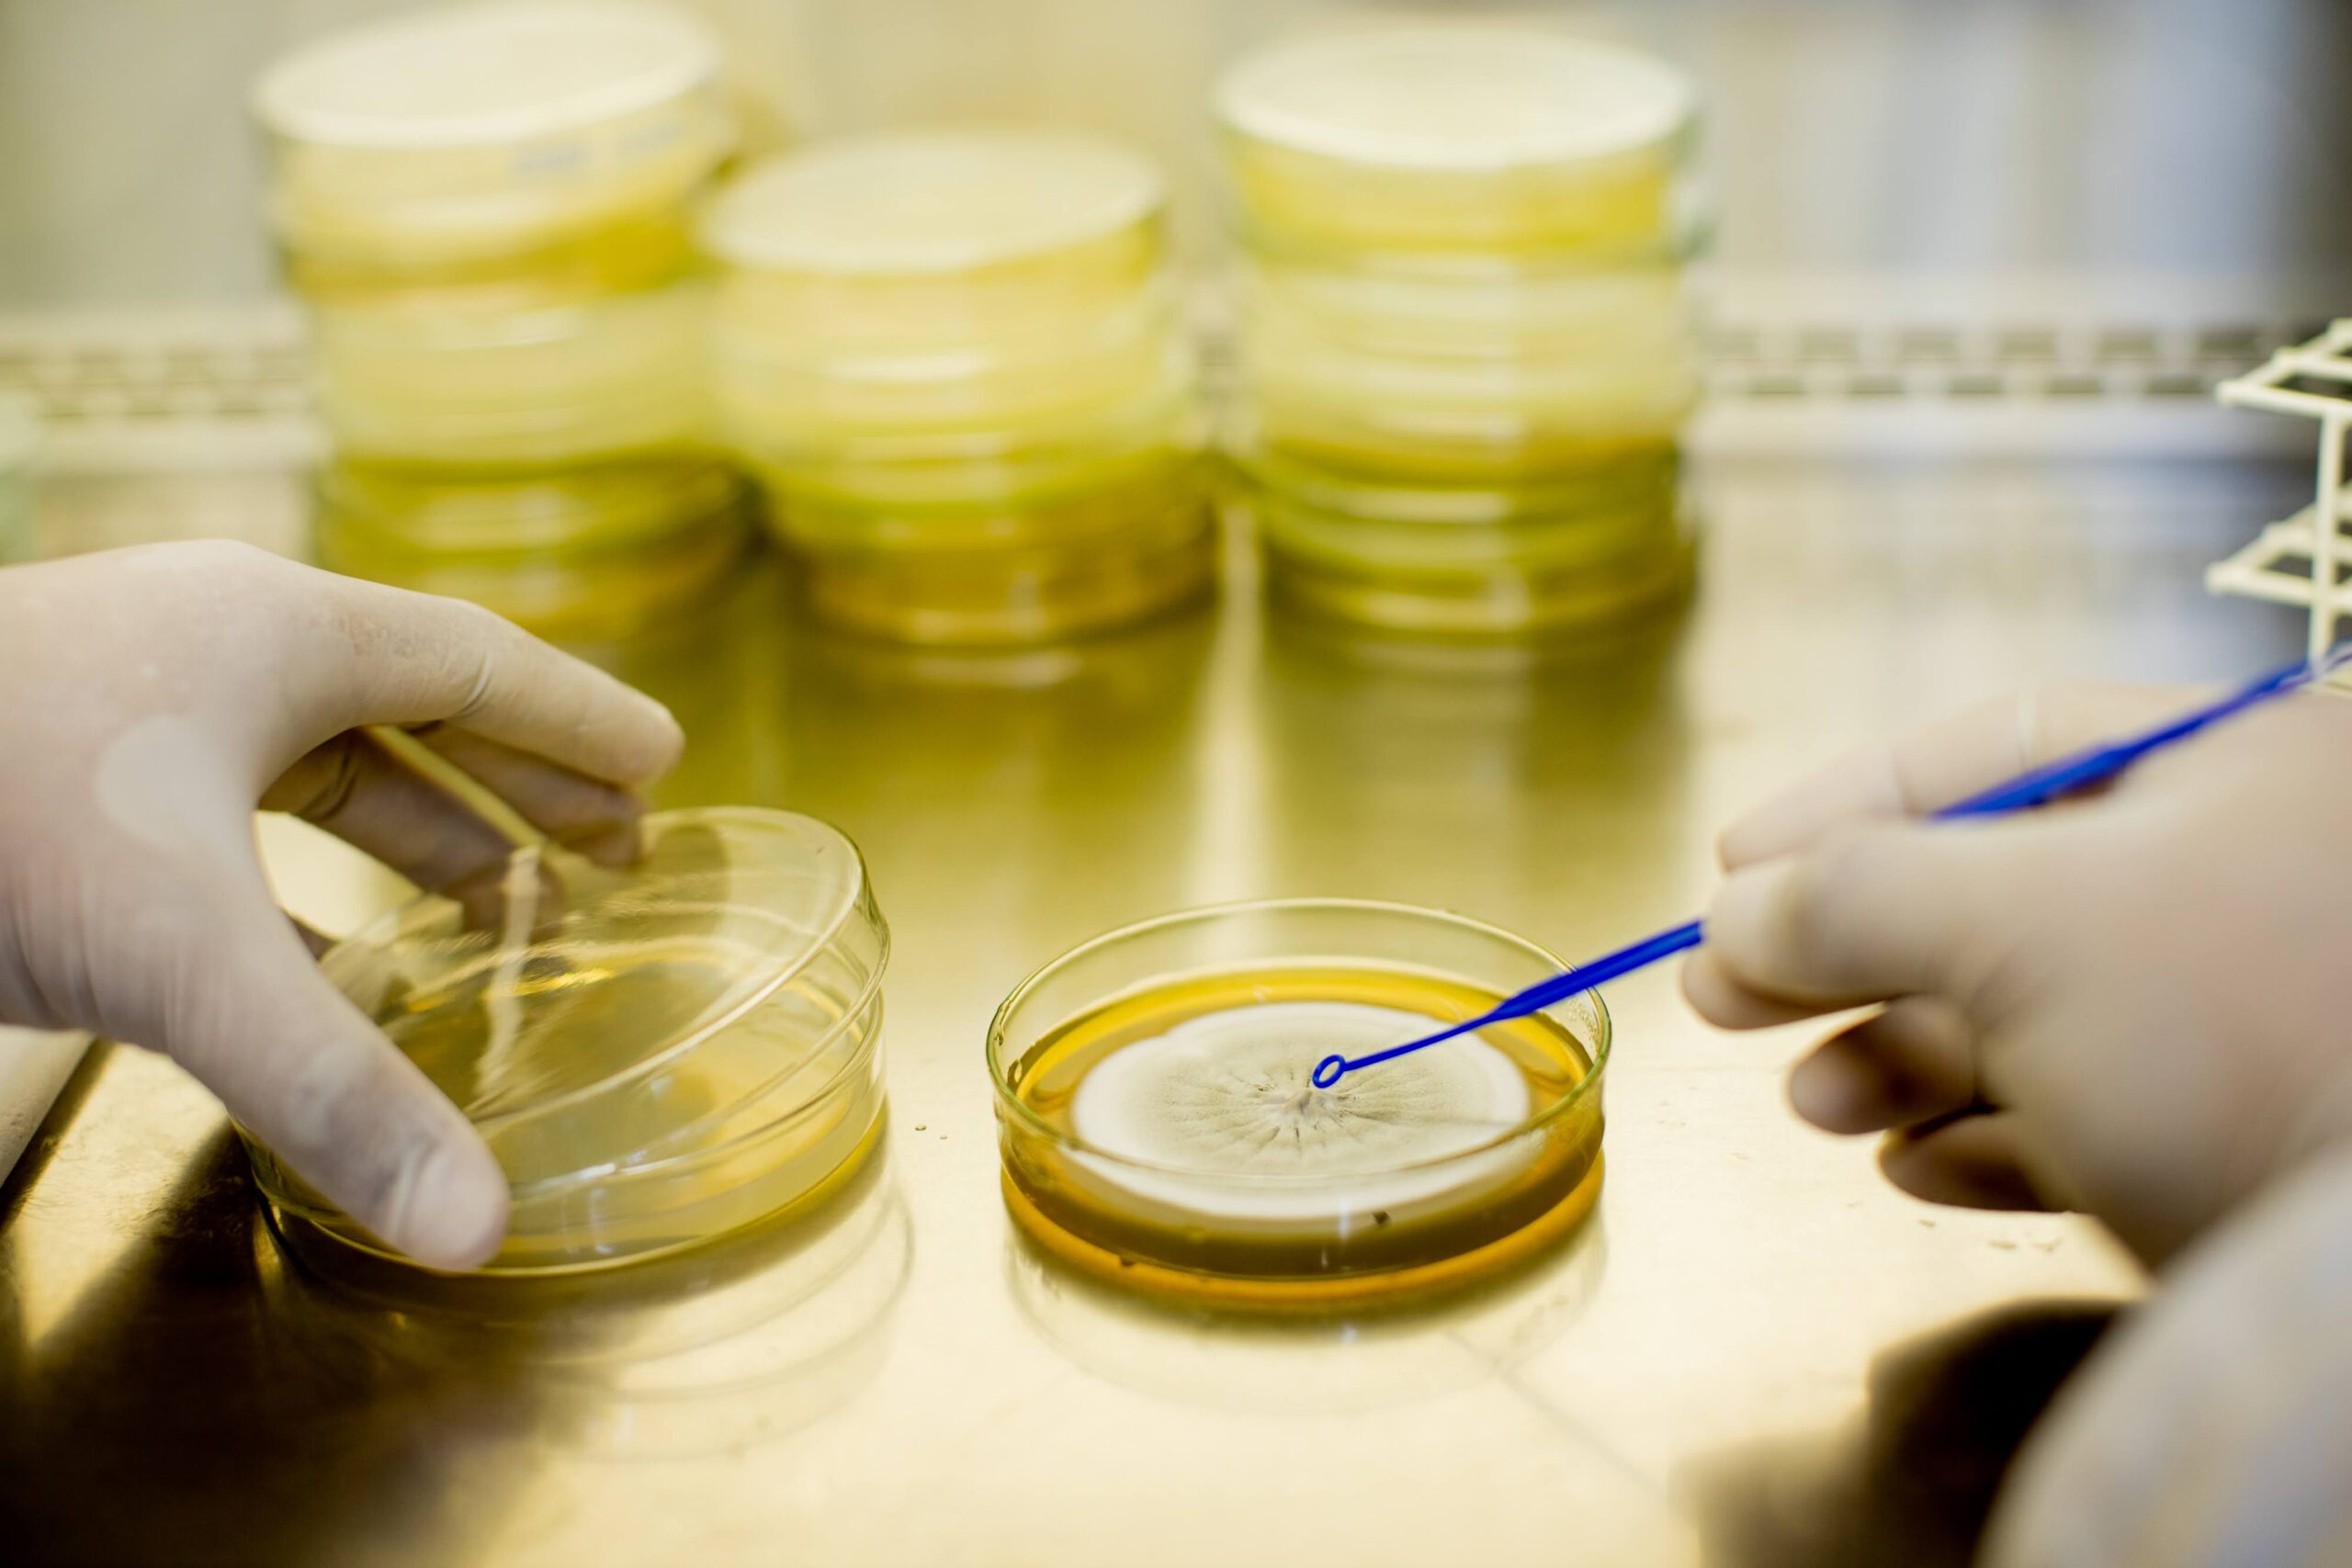

Vacine já: Governo do Amazonas e Prefeitura de Manaus realizam campanha contra a Covid-19 em supermercados da capital
Ação ocorre nesta sexta-feira (13/01) e sábado (14/01)

Ação ocorre nesta sexta-feira (13/01) e sábado (14/01)

Prédio foi depredado durante atos golpistas

nscrições do concurso vão até dia 27 de janeiro
estudo amparado pela Fapeam foi responsável pela catalogação de 114 linhagens de fungos

As inscrições iniciam no dia 30 de janeiro de 2023.

Dados não se referem a sigilos sob análise na CGU

A praça da Saudade, um dos locais públicos mais antigos da cidade,

O evento é coordenado pela Comissão de Frente da escola e promete movimentar o público LGBT.

Técnicos realizaram análise da estrutura e da água de dois novos viveiros construídos para criação e reprodução de alevinos

O projeto de biomonitoramento, amparado pela Fapeam, fez a verificação com o peixe Acará Duas Pintas
Receba os principais destaques todos os dias no seu email.
| Cookie | Duração | Descrição |
|---|---|---|
| cookielawinfo-checkbox-analytics | 11 months | This cookie is set by GDPR Cookie Consent plugin. The cookie is used to store the user consent for the cookies in the category "Analytics". |
| cookielawinfo-checkbox-functional | 11 months | The cookie is set by GDPR cookie consent to record the user consent for the cookies in the category "Functional". |
| cookielawinfo-checkbox-necessary | 11 months | This cookie is set by GDPR Cookie Consent plugin. The cookies is used to store the user consent for the cookies in the category "Necessary". |
| cookielawinfo-checkbox-others | 11 months | This cookie is set by GDPR Cookie Consent plugin. The cookie is used to store the user consent for the cookies in the category "Other. |
| cookielawinfo-checkbox-performance | 11 months | This cookie is set by GDPR Cookie Consent plugin. The cookie is used to store the user consent for the cookies in the category "Performance". |
| viewed_cookie_policy | 11 months | The cookie is set by the GDPR Cookie Consent plugin and is used to store whether or not user has consented to the use of cookies. It does not store any personal data. |